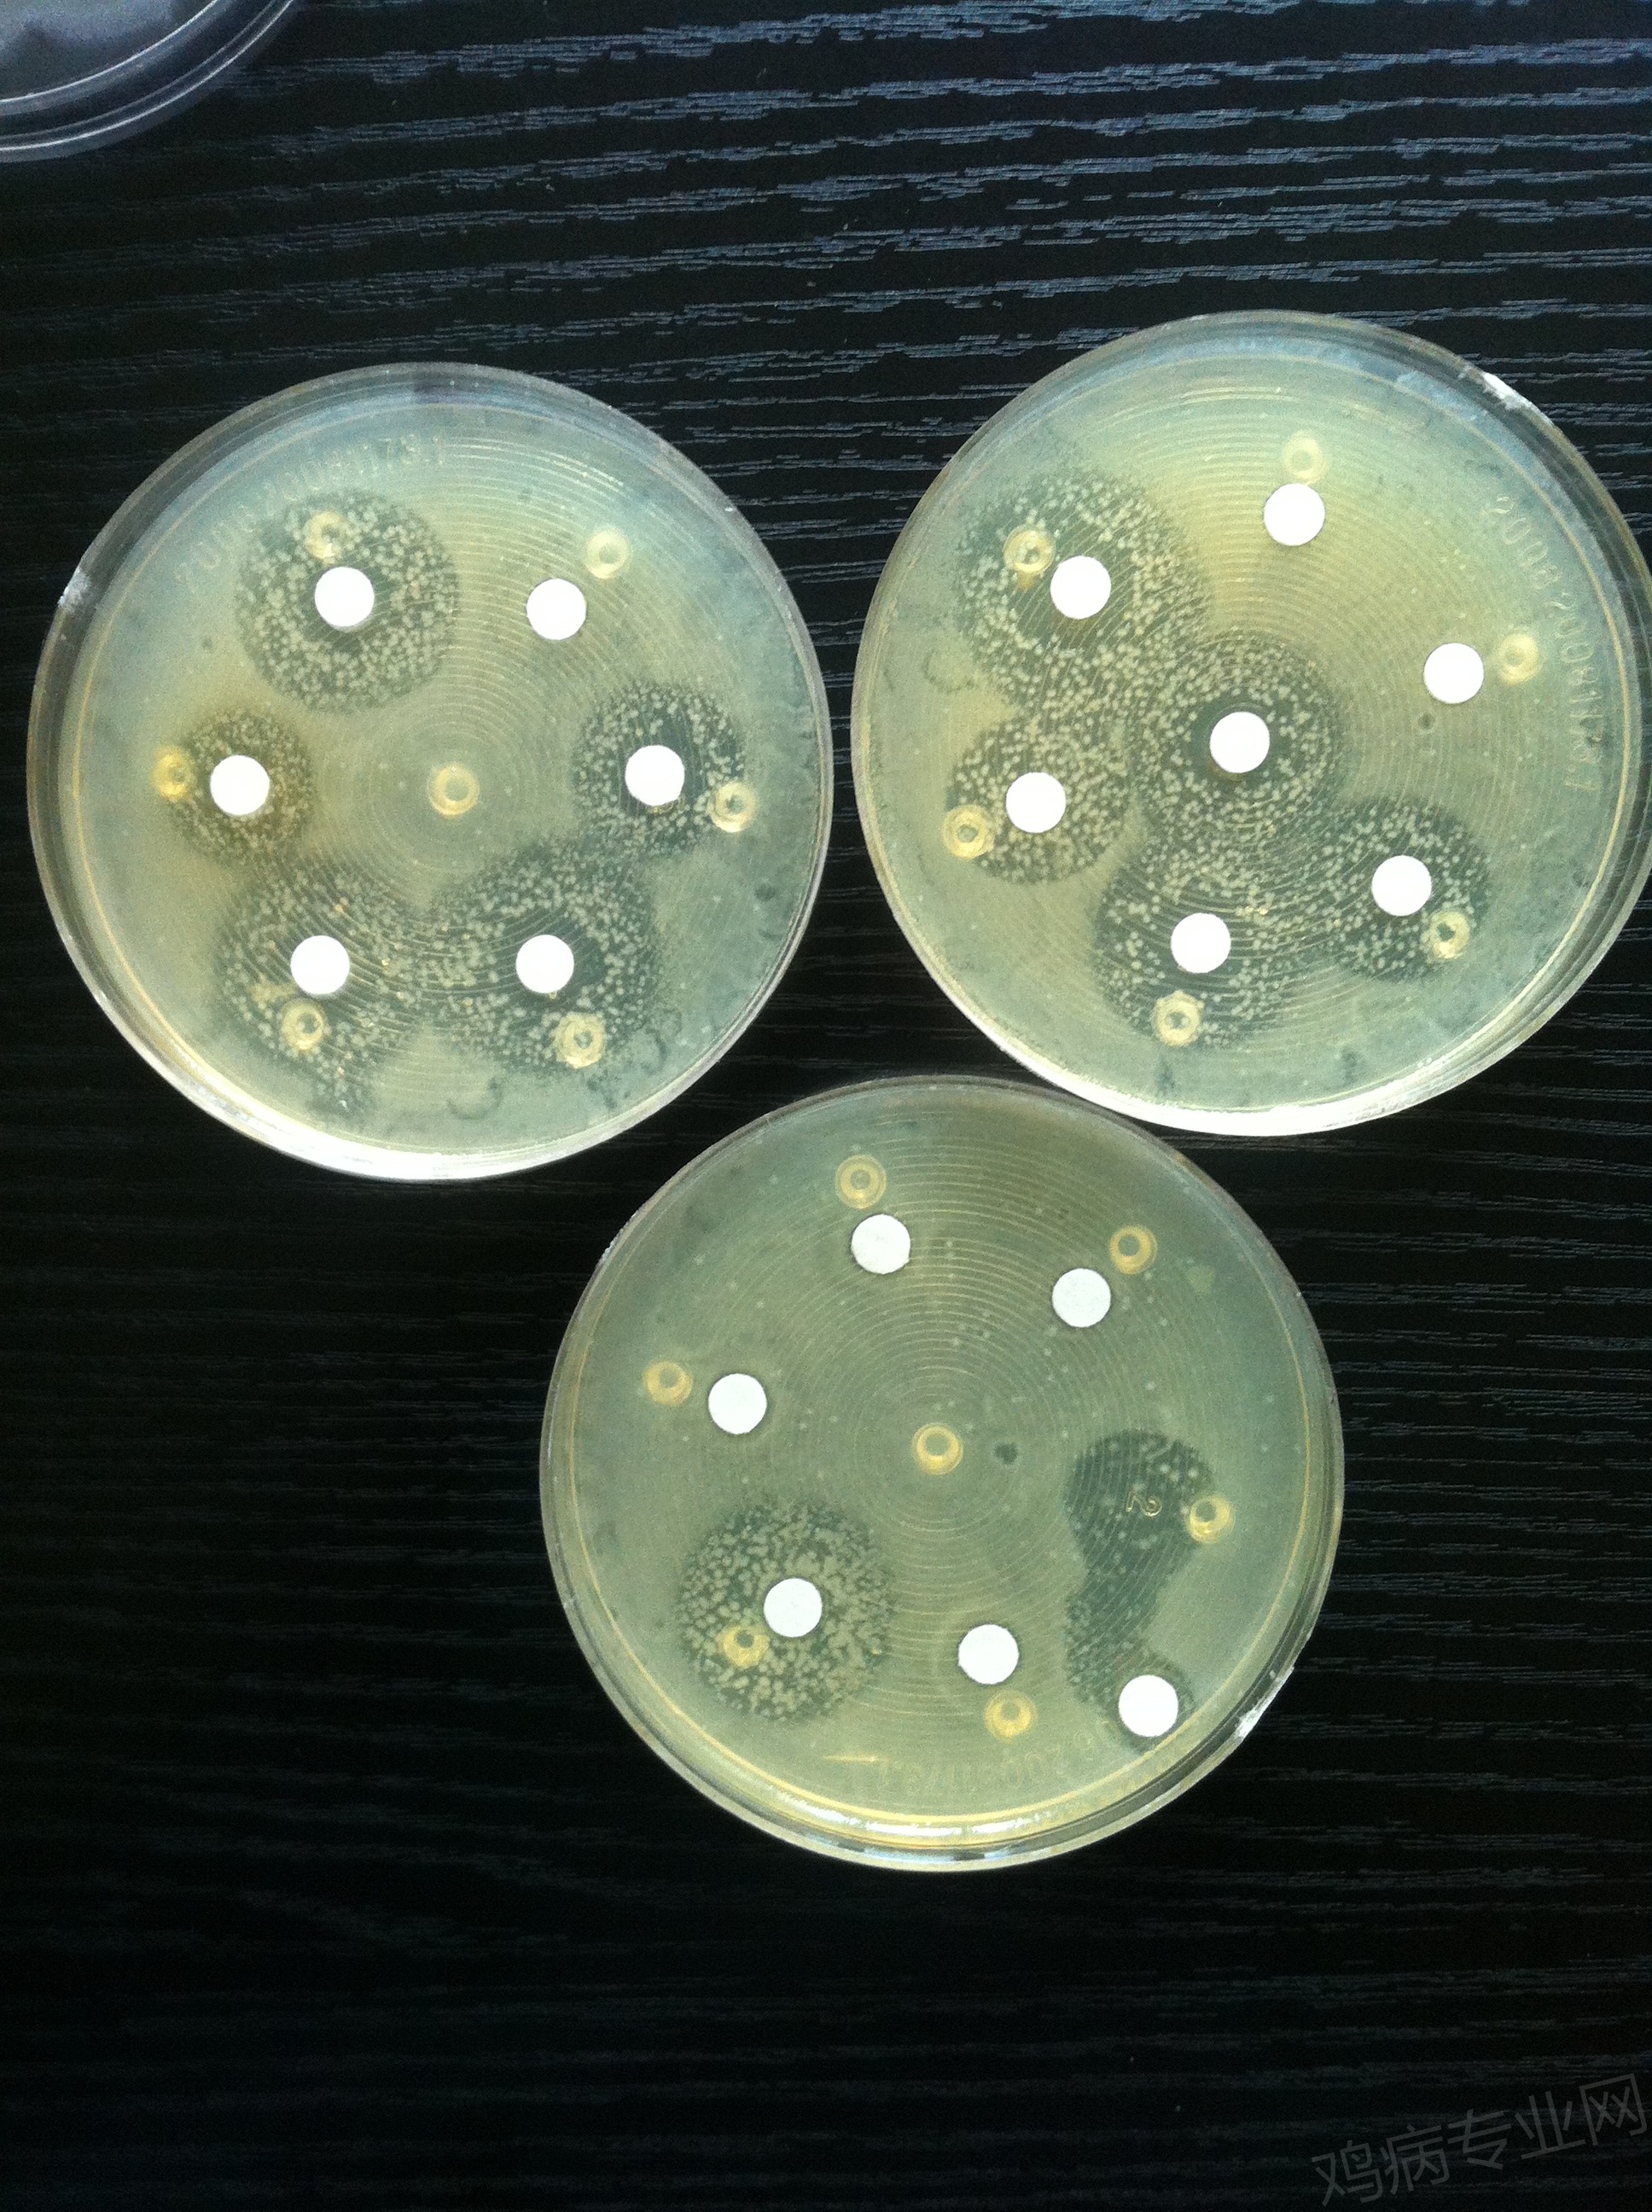
药敏结果不理想,抑菌圈很大,但不彻底,可能是混合感染

抑菌圈实验

抑菌圈
图片尺寸2667x2000
抑菌圈演示测试图片
图片尺寸456x452
求助抑菌圈实验
图片尺寸1080x810
进行细菌抑菌圈检测,结果如下图: 实验奈诺莫纳米抗菌袜样品对多种不
图片尺寸640x632
【求助】求抑菌圈实验指导
图片尺寸750x750
求助一下精油的抑菌圈实验-1
图片尺寸900x678
请教:关于抗生素与细菌抑菌圈的问题
图片尺寸560x420
求助一下精油的抑菌圈实验-2
图片尺寸680x900
8*10mm/8.0mm药敏实验抑菌圈实验抗生素效价,100只/盒.
图片尺寸960x960
抗菌实验—抑菌圈法
图片尺寸800x600
求助一下精油的抑菌圈实验
图片尺寸680x900
求抑菌圈实验指导
图片尺寸601x800
第一次活性特别好,抑菌圈是透明的 另外,我们实验室其他人和我用
图片尺寸800x599
抑菌圈实验-孤独の吡哆醛-抗菌实验-哔哩哔哩视频
图片尺寸1728x1080
【求助】求抑菌圈实验指导
图片尺寸600x800
1.34s自动完成6组抑菌圈测量和各类标记
图片尺寸3320x2196
药敏结果不理想,抑菌圈很大,但不彻底,可能是混合感染
图片尺寸1936x2592
肽素生物植物乳酸菌(副干酪乳杆菌)培养物抑菌实验报告
图片尺寸449x454
通过抑菌实验,可以测定一个药物的最低抑菌浓度,用以评价该药物的抑菌
图片尺寸639x433
青霉素抑菌圈边缘试验检测β-内酰胺酶产生株;注:阳性为青霉素抑菌圈
图片尺寸744x709